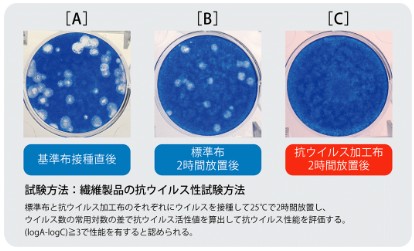

抗ウイルス加工カーテン通販|匠工房
目次
抗ウイルス加工カーテン通販
ウイルスをほぼ除去できる安全性の高いカーテンです。
全国通販も対応いたします。
相模原・町田近郊は無料採寸サービスも可能です。
メーカーHPはこちらをご参照ください。
抗ウイルス加工
ドレープカーテン

ドレープE8280/レースE8364
繊維を清潔に保つ抗ウイルス加工の機能性カーテンです。
制菌性の有しており、医療・教育・福祉施設に効果的です。
繊維製品の抗ウイルス性試験方法

SEK抗ウイルス加工剤の安全性基準

抗ウイルス加工マーク
抗ウイルス加工
ドレープカーテン生地見本
![]() E8280 遮光2級 |
![]() E8281 遮光2級 |
![]() E8282 遮光2級 |
注意
- 抗ウイルス加工は、病気の治療や予防を目的とするものではありません。
- 抗ウイルス性試験は、ウイルス株:ATCC VR-1679(エンベロープ有)を25℃で2時間放置して実施しています。
- 抗ウイルス加工は、ウイルスの働きを抑制するものではありません。
- コロナウイルスに効果があるかは実証されていません。
抗ウイルス加工
ドレープカーテン価格表
品番E8280・E8281・E8282
スタイリッシュウェーブ縫製(KH)約2倍ヒダ・共生地タッセル込み
| 幅㎝→ 高さ㎝↓ |
|---|
| 〜100 |
| 101〜120 |
| 121〜140 |
| 141〜160 |
| 161〜180 |
| 181~200 |
| 201~220 |
| 221~240 |
| 241~260 |
| 261~280 |
| 281~300 |
| KE1.5倍ヒダ |
| 76〜150 2巾 |
151〜225 3巾 |
226〜300 4巾 |
301〜375 5巾 |
376〜450 6巾 |
|---|---|---|---|---|
| 11,790 | 17,460 | 23,130 | 28,800 | 34,470 |
| 13,410 | 19,890 | 26,370 | 32,850 | 39,330 |
| 15,030 | 22,320 | 29,610 | 44,190 | 51,480 |
| 16,650 | 24,750 | 32,850 | 40,950 | 49,050 |
| 18,270 | 27,180 | 36,090 | 45,000 | 53,910 |
| 19,890 | 29,610 | 39,330 | 49,050 | 58,770 |
| 21,510 | 32,040 | 42,570 | 53,100 | 63,630 |
| 23,130 | 34,470 | 45,810 | 57,150 | 68,490 |
| 24,750 | 36,900 | 49,050 | 61,200 | 73,350 |
| 26,370 | 39,330 | 52,290 | 65,250 | 78,210 |
| 27,990 | 41,760 | 55,530 | 69,300 | 83,070 |
| 101~200 | 201~300 | 301~400 | 401~500 | 501~600 |
※横方向にスクロールします。
※消費税別です。
※メーカー直送の場合送料は込みとなります。
抗ウイルス加工
ドレープカーテン生地見本
![]() E8283 遮光3級 |
![]() E8284 遮光3級 |
注意
- 抗ウイルス加工は、病気の治療や予防を目的とするものではありません。
- 抗ウイルス性試験は、ウイルス株:ATCC VR-1679(エンベロープ有)を25℃で2時間放置して実施しています。
- 抗ウイルス加工は、ウイルスの働きを抑制するものではありません。
- コロナウイルスに効果があるかは実証されていません。
抗ウイルス加工
ドレープカーテン価格表
品番E8283・E8284
スタイリッシュウェーブ縫製(KH)約2倍ヒダ・共生地タッセル込み
| 幅㎝→ 高さ㎝↓ |
|---|
| 〜100 |
| 101〜120 |
| 121〜140 |
| 141〜160 |
| 161〜180 |
| 181~200 |
| 201~220 |
| 221~240 |
| 241~260 |
| 261~280 |
| 281~300 |
| KE1.5倍ヒダ |
| 76〜150 2巾 |
151〜225 3巾 |
226〜300 4巾 |
301〜375 5巾 |
376〜450 6巾 |
|---|---|---|---|---|
| 15,570 | 23,230 | 30,690 | 38,250 | 45,810 |
| 17,730 | 26,370 | 35,010 | 43,650 | 52,290 |
| 19,890 | 29,610 | 39,330 | 49,050 | 58,770 |
| 22,050 | 32,850 | 43,650 | 54,450 | 65,250 |
| 24,210 | 36,090 | 47,970 | 59,850 | 71,730 |
| 26,370 | 39,330 | 52,290 | 65,250 | 78,210 |
| 28,530 | 42,570 | 56,610 | 70,650 | 84,690 |
| 30,690 | 45,810 | 60,930 | 76,050 | 91,170 |
| 32,850 | 49,050 | 65,250 | 81,450 | 97,650 |
| 35,010 | 52,290 | 69,570 | 86,850 | 104,130 |
| 37,170 | 55,530 | 73,890 | 92,250 | 110,610 |
| 101~200 | 201~300 | 301~400 | 401~500 | 501~600 |
※横方向にスクロールします。
※消費税別です。
※メーカー直送の場合送料は込みとなります。
抗ウイルス加工
レースカーテン

E-8364 ミラーカーテン・遮熱効果あり

注意
- 抗ウイルス加工は、病気の治療や予防を目的とするものではありません。
- 抗ウイルス性試験は、ウイルス株:ATCC VR-1679(エンベロープ有)を25℃で2時間放置して実施しています。
- 抗ウイルス加工は、ウイルスの働きを抑制するものではありません。
- コロナウイルスに効果があるかは実証されていません。
抗ウイルス加工レースカーテン価格表
品番E8364
スタイリッシュウェーブ縫製(KH)約2倍ヒダ・タッセルなし
| 幅㎝→ 高さ㎝↓ |
|---|
| 〜100 |
| 101〜120 |
| 121〜140 |
| 141〜160 |
| 161〜180 |
| 181~200 |
| 201~220 |
| 221~240 |
| 241~260 |
| 261~280 |
| 281~300 |
| KE1.5倍ヒダ |
| 76〜150 2巾 |
151〜225 3巾 |
226〜300 4巾 |
301〜375 5巾 |
376〜450 6巾 |
|---|---|---|---|---|
| 7,200 | 10,800 | 14,400 | 18,000 | 21,600 |
| 8,280 | 12,420 | 16,560 | 20,700 | 24,840 |
| 9,270 | 13,905 | 18,540 | 23,175 | 27,810 |
| 10,260 | 15,390 | 20,520 | 25,650 | 30,780 |
| 11,340 | 17,010 | 22,680 | 28,350 | 34,020 |
| 12,330 | 18,495 | 24,660 | 30,825 | 36,990 |
| 13,410 | 20,115 | 26,820 | 33,525 | 40,230 |
| 14,400 | 21,600 | 28,800 | 36,000 | 43,200 |
| 15,390 | 23,85 | 30,780 | 38,475 | 46,170 |
| 16,470 | 24,705 | 32,940 | 41,175 | 49,410 |
| 17,460 | 26,190 | 34,920 | 43,650 | 52,380 |
| 101~200 | 201~300 | 301~400 | 401~500 | 501~600 |
※横方向にスクロールします。
※消費税別です。
※メーカー直送の場合送料は込みとなります。
通販対応可能

お客様にて採寸可能な場合はメーカー直送・送料無料にてお届けすることも可能です。
カーテンの採寸方法はこちら
現地採寸見積りは無料です。

当店にお越しいただくことが難しい場合は、見本帳やサンプルを持参して直接現場に赴くことも可能です。(相模原・町田近郊限定)採寸後すぐに概算金額を算出することも可能です。
1窓でも出張しますのでお気兼ねなくご用命ください。

相模原・町田に限りましてカーテンの出張採寸見積りは1窓から無料にて承っております。お困りの際はお気軽にご相談ください。
とにかく安い

オーダーカーテン50%OFF~、カーテンレールの取付け工事費用は相模原・町田地域は取付け工事費無料
※カーテンレールの製品代金は別途となります。
お支払はカードでもOK
対面販売のみに限りましてお支払いは当店でも現場でもカード支払いができます。
詳しくはお問い合わせください。
現地採寸お見積りは無料です。




